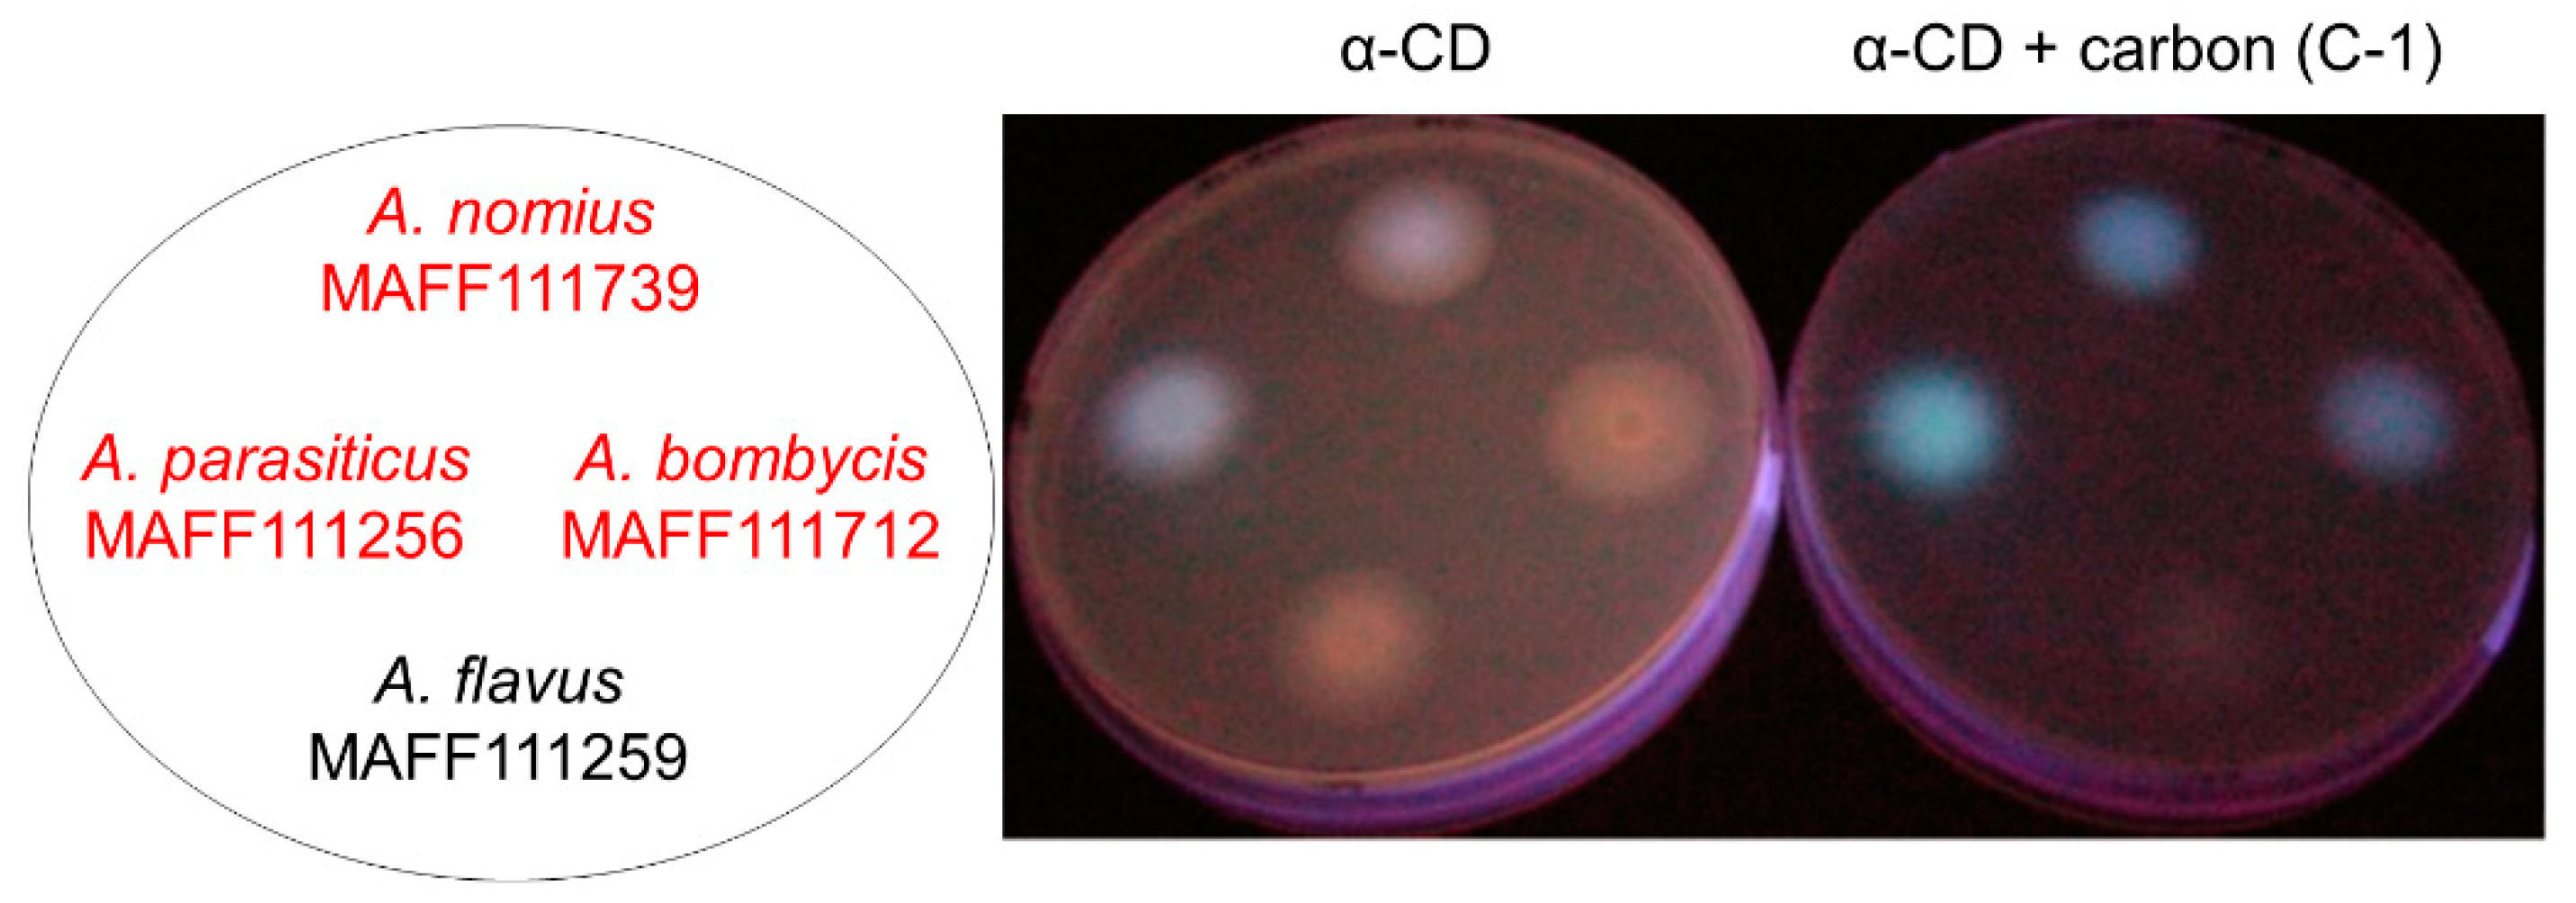
Toxins 11 00140 g001

Metal Ions in Activated Carbon Improve the Detection Efficiency of Aflatoxin-Producing Fungi
Abstract
1. Introduction
2. Results
2.1. Comparative Analysis of the Addition of Each Carbon to the Culture Media
2.1.1. Evaluation of Carbon Addition
2.1.2. Effects of Carbon Addition on Fungal Growth and AF Production
2.2. Analysis of Trace Element Composition
2.3. Effect of Trace Element Addition on AF Production
3. Discussion
4. Conclusions
5. Materials and Methods
5.1. Fungal Species
5.2. Culture Conditions and Apparatus
5.3. Measurement of Light Scattering
5.4. High-Performance Liquid Chromatography
5.5. ICP-OES and ICP-MS Analyses
5.6. Statistical Analyses
Author Contributions
Funding
Acknowledgments
Conflicts of Interest
References
- Guengerich, F.P.; Johnson, W.W.; Ueng, Y.F.; Yamazaki, H.; Shimada, T. In Involvement of cytochrome P450, glutathione S-transferase, and epoxide hydrolase in the metabolism of aflatoxin B-1 and relevance to risk of human liver cancer. Environ. Health Perspect. 1996, 104, 557–562. [Google Scholar]
- Abrar, M.; Anjum, F.M.; Butt, M.S.; Pasha, I.; Randhawa, M.A.; Saeed, F.; Waqas, K. Aflatoxins: Biosynthesis, occurrence, toxicity, and remedies. Crit. Rev. Food Sci. Nutr. 2013, 53, 862–874. [Google Scholar] [CrossRef] [PubMed]
- Medina, A.; Rodriguez, A.; Magan, N. Effect of climate change on Aspergillus flavus and aflatoxin B1 production. Front. Microbiol. 2014, 5, 348. [Google Scholar] [CrossRef] [PubMed]
- Levin, R.E. PCR detection of aflatoxin producing fungi and its limitations. Int. J. Food. Microbiol. 2012, 156, 1–6. [Google Scholar] [CrossRef]
- Carbone, I.; Ramirez-Prado, J.H.; Jakobek, J.L.; Horn, B.W. Gene duplication, modularity and adaptation in the evolution of the aflatoxin gene cluster. BMC. Evol. Biol. 2007, 7, 111. [Google Scholar] [CrossRef] [PubMed]
- Pitt, J.I.; Hocking, A.D.; Glenn, D.R. An improved medium for the detection of Aspergillus flavus and A. parasiticus. J. Appl. Bacteriol. 1983, 54, 109–114. [Google Scholar] [CrossRef]
- Saito, M.; Machida, S. A rapid identification method for aflatoxin-producing strains of Aspergillus flavus and A. parasiticus by ammonia vapor. Mycoscience 1999, 40, 205–208. [Google Scholar] [CrossRef]
- Yabe, K.; Hatabayashi, H.; Ikehata, A.; Zheng, Y.; Kushiro, M. Development of the dichlorvos- ammonia (DV-AM) method for the visual detection of aflatoxigenic fungi. Appl. Microbiol. Biotechnol. 2015, 99, 10681–10694. [Google Scholar] [CrossRef]
- Hara, S.; Fennell, D.I.; Hesseltine, C.W. Aflatoxin-producing strains of Aspergillus flavus detected by fluorescence of agar medium under ultraviolet light. Appl. Microbiol. 1974, 27, 1118–1123. [Google Scholar]
- Vazquez, M.; Cepeda, A.; Prognon, P.; Mahuzier, G.; Blais, J. Cyclodextrins as modifiers of the luminescence characteristics of aflatoxins. Analytica. Chimica. Acta. 1991, 255, 343–350. [Google Scholar] [CrossRef]
- Fente, C.A.; Ordaz, J.J.; Vázquez, B.I.; Franco, C.M.; Cepeda, A. New additive for culture media for rapid identification of aflatoxin-producing Aspergillus strains. Appl. Environ. Microbiol. 2001, 67, 4858–4862. [Google Scholar] [CrossRef] [PubMed]
- Jaimez Ordaz, J.; Fente, C.A.; Vázquez, B.I.; Franco, C.M.; Cepeda, A. Development of a method for direct visual determination of aflatoxin production by colonies of the Aspergillus flavus group. Int. J. Food. Microbiol. 2003, 83, 219–225. [Google Scholar] [CrossRef]
- Rahimi, P.; Sharifnabi, B.; Bahar, M. Detection of Aflatoxin in Aspergillus Species Isolated from Pistachio in Iran. J. Phytopathol. 2008, 156, 15–20. [Google Scholar] [CrossRef]
- Suzuki, T.; Iwahashi, Y. Addition of Carbon to the Culture Medium Improves the Detection Efficiency of Aflatoxin Synthetic Fungi. Toxins (Basel) 2016, 8, 338. [Google Scholar] [CrossRef]
- Ikuo, A. Production methods of activated carbon. TANSO 2006, 225, 373–381. [Google Scholar]
- Rovamo, J.; Koljonen, T.; Näsänen, R. A new psychophysical method for determining the photopic spectral-luminosity function of the human eye. Vision. Res. 1996, 36, 2675–2680. [Google Scholar] [CrossRef]
- Sharpe, L.T.; Stockman, A.; Jagla, W.; Jägle, H. A luminous efficiency function, V*(λ), for daylight adaptation. J. Vis. 2005, 5, 948–968. [Google Scholar] [CrossRef]
- Takeshita, N.; Evangelinos, M.; Zhou, L.; Serizawa, T.; Somera-Fajardo, R.A.; Lu, L.; Takaya, N.; Nienhaus, G.U.; Fischer, R. Pulses of Ca2+ coordinate actin assembly and exocytosis for stepwise cell extension. Proc. Natl. Acad. Sci. USA 2017, 114, 5701–5706. [Google Scholar] [CrossRef]
- Marsh, P.B.; Simpson, M.E.; Trucksess, M.W. Effects of trace metals on the production of aflatoxins by Aspergillus parasiticus. Appl. Microbiol. 1975, 30, 52–57. [Google Scholar]
- Cuero, R.; Ouellet, T. Metal ions modulate gene expression and accumulation of the mycotoxins aflatoxin and zearalenone. J. Appl. Microbiol. 2005, 98, 598–605. [Google Scholar] [CrossRef]
- NRRL Medium No. 8, Czapek’s Solution Agar (CZA). Available online: https://nrrl.ncaur.usda.gov/forms/NRRL_ Medium_8.pdf (accessed on 8 June 2018).
- Reddy, T.; Viswanathan, L.; Venkitasubramanian, T. High aflatoxin production on a chemically defined medium. Appl. Microbiol. 1971, 22, 393–396. [Google Scholar] [PubMed]
- Cai, J.; Zeng, H.; Shima, Y.; Hatabayashi, H.; Nakagawa, H.; Ito, Y.; Adachi, Y.; Nakajima, H.; Yabe, K. Involvement of the nadA gene in formation of G-group aflatoxins in Aspergillus parasiticus. Fungal. Genet. Biol. 2008, 45, 1081–1093. [Google Scholar] [CrossRef] [PubMed]
- Aoyagi, K.; Takeshige, K.; Sumimoto, H.; Nunoi, H.; Minakami, S. Role of Mg2+ in activation of NADPH oxidase of human neutrophils: Evidence that Mg2+ acts through G-protein. Biochem. Biophys. Res. Commun. 1992, 186, 391–397. [Google Scholar] [CrossRef]
- Cross, A.R.; Erickson, R.W.; Ellis, B.A.; Curnutte, J.T. Spontaneous activation of NADPH oxidase in a cell-free system: Unexpected multiple effects of magnesium ion concentrations. Biochem. J. 1999, 338 Pt 1, 229–233. [Google Scholar] [CrossRef]
- La Piana, G.; Gorgoglione, V.; Laraspata, D.; Marzulli, D.; Lofrumento, N.E. Effect of magnesium ions on the activity of the cytosolic NADH/cytochrome c electron transport system. FEBS J. 2008, 275, 6168–6179. [Google Scholar] [CrossRef] [PubMed]
- Yabe, K.; Nakamura, H.; Ando, Y.; Terakado, N.; Nakajima, H.; Hamasaki, T. Isolation and characterization of Aspergillus parasiticus mutants with impaired aflatoxin production by a novel tip culture method. Appl. Environ. Microbiol. 1988, 54, 2096–2100. [Google Scholar] [PubMed]
- Ministry of Agriculture, Forestry and Fisheries. Available online: http://www.maff.go.jp/j/seisan/ boeki/beibaku_anzen/kabikabidokukensa_surveillance/pdf/110816-3af.pdf (accessed on 8 June 2016).

| Set No. | Description | Cat. No. 1 | Particle size | Material, Activation Method | pH | Supplier |
|---|---|---|---|---|---|---|
| C-1 | Powder, Neutral | 031-18103 | <150 μm | Peat, Steam activation | 6.0~7.2 | FUJIFILM Wako Pure Chemical |
| C-2 | Powder, Basic | 032-18091 | <150 μm | Peat, Steam activation | 10 | FUJIFILM Wako Pure Chemical |
| C-3 | Powder | 031-02135 | <300 μm | Sawn wood, Acid washed | 6.0 | FUJIFILM Wako Pure Chemical |
| C-4 | Granule | 01084-12 | 3.35~4.75 mm | Coal, Coconut shell, Steam activation | 6.0~8.0 | Kanto Chemical |
| C-5 | Powder | 08304-08 | <75 μm | Sawn wood, Steam activation | 9.0~11.0 | Kanto Chemical |
| C-6 | Powder | 08305-08 | <150 μm | Coconut shell, Steam activation | 6.0~8.0 | Kanto Chemical |
| C-7 | Powder | 01085-02 | 20 μm | Sawn wood, Steam activation | 6.0~8.0 | Kanto Chemical |
| C-8 | Powder | 07909-65 | <40 μm | Sawn wood, Acid washed | 5.0~8.0 | Nacalai tesque |
| C-9 | Powder, Darco G-60 | 537-02241 | 45~150 μm | Natural product, <10 % silica, 2 | 6.0~8.0 | FUJIFILM Wako Pure Chemical |
| C-10 | Powder, Norit(R) A pract. | 30890.01 | 45~75 μm | Peat, Acid washed | 6.0~8.0 | FUJIFILM Wako Pure Chemical |
| PDA with 3 g·L−1 α-CD | ||||||||||
|---|---|---|---|---|---|---|---|---|---|---|
| — | C-1 | C-2 | C-3 | C-4 | C-5 | C-6 | C-7 | C-8 | C-9 | C-10 |
| ± | +++ | ++ | ± | ++ | +++ | + | ± | + | + | + |
| * | α-CD | ||||||||||
|---|---|---|---|---|---|---|---|---|---|---|---|
| ** | C-1 | C-2 | C-3 | C-4 | C-5 | C-6 | C-7 | C-8 | C-9 | C-10 | |
| 100 ± 2.3 | 145.9 ± 1.9 | 13.3 ± 1.1 | 12.8 ± 2.9 | 51.4 ± 2.4 | 83.5 ± 2.4 | 45.0 ± 1.6 | 29.8 ± 1.3 | 54.2 ± 10.7 | 22.7 ± 1.8 | −15.4 ± 2.7 | 31.5 ± 1.8 |
| — * | C-1 | C-2 | C-3 | C-4 | C-5 | C-6 | C-7 | C-8 | C-9 | C-10 | |
|---|---|---|---|---|---|---|---|---|---|---|---|
| MAFF 111712 | 1.75 ± 0.13 | 1.72 ± 0.25 | 1.58 ± 0.12 | 1.35 ± 0.36 | 1.50 ± 0.17 | 1.92 ± 0.19 | 1.62 ± 0.12 | 1.71 ± 0.33 | 1.53 ± 0.24 | 1.69 ± 0.23 | 1.77 ± 0.37 |
| MAFF 111739 | 2.04 ± 0.38 | 2.33 ± 0.19 | 2.28 ± 0.21 | 1.42 ± 0.21 | 1.73 ± 0.21 | 2.45 ± 0.36 | 1.92 ± 0.23 | 1.97 ± 0.16 | 1.57 ± 0.34 | 2.25 ± 0.14 | 2.11 ± 0.27 |
| Aspergillus bombycis MAFF111712 | |||||||||||
| — * | C-1 | C-2 | C-3 | C-4 | C-5 | C-6 | C-7 | C-8 | C-9 | C-10 | |
| AFG1 | 5.44 ± 0.69 | 8.28 ± 1.04 | 6.25 ± 1.63 | 4.11 ± 0.21 | 7.67 ± 1.22 | 5.97 ± 0.44 | 6.70 ± 1.60 | 5.91 ± 1.67 | 5.26 ± 0.81 | 6.72 ± 1.58 | 5.51 ± 0.62 |
| AFB1 | 4.05 ± 0.53 | 3.55 ± 0.97 | 2.90 ± 0.66 | 3.00 ± 0.64 | 3.62 ± 0.35 | 2.75 ± 0.11 | 3.49 ± 0.50 | 3.42 ± 0.47 | 2.33 ± 0.49 | 3.14 ± 0.79 | 2.96 ± 0.18 |
| AFG2 | 0.06 ± 0.01 | 0.06 ± 0.01 | 0.05 ± 0.01 | 0.06 ± 0.01 | 0.10 ± 0.01 | 0.07 ± 0.02 | 0.11 ± 0.02 | 0.10 ± 0.04 | 0.11 ± 0.03 | 0.14 ± 0.06 | 0.12 ± 0.03 |
| AFB2 | 0.10 ± 0.01 | 0.05 ± 0.01 | 0.05 ± 0.01 | 0.09 ± 0.03 | 0.10 ± 0.00 | 0.07 ± 0.02 | 0.13 ± 0.03 | 0.13 ± 0.03 | 0.10 ± 0.02 | 0.13 ± 0.05 | 0.13 ± 0.03 |
| Aspergillus nomius MAFF111739 | |||||||||||
| — * | C-1 | C-2 | C-3 | C-4 | C-5 | C-6 | C-7 | C-8 | C-9 | C-10 | |
| AFG1 | 0.18 ± 0.03 | 0.31 ± 0.12 | 0.30 ± 0.09 | 0.18 ± 0.08 | 0.49 ± 0.03 | 0.38 ± 0.18 | 0.26 ± 0.05 | 0.18 ± 0.07 | 0.22 ± 0.09 | 0.15 ± 0.04 | 0.13 ± 0.03 |
| AFB1 | 1.60 ± 0.24 | 0.59 ± 0.19 | 0.43 ± 0.11 | 1.55 ± 0.48 | 1.91 ± 0.10 | 1.02 ± 0.38 | 1.23 ± 0.06 | 1.10 ± 0.44 | 1.01 ± 0.31 | 0.57 ± 0.08 | 0.69 ± 0.16 |
| AFG2 | 0.00 ± 0.00 | 0.00 ± 0.00 | 0.00 ± 0.00 | 0.00 ± 0.00 | 0.00 ± 0.00 | 0.00 ± 0.00 | 0.00 ± 0.00 | 0.00 ± 0.00 | 0.00 ± 0.00 | 0.00 ± 0.00 | 0.00 ± 0.00 |
| AFB2 | 0.01 ± 0.00 | 0.00 ± 0.00 | 0.00 ± 0.00 | 0.02 ± 0.01 | 0.01 ± 0.00 | 0.01 ± 0.00 | 0.01 ± 0.00 | 0.01 ± 0.01 | 0.02 ± 0.01 | 0.01 ± 0.00 | 0.01 ± 0.00 |
| Set No. | P | K | Ca | Mg | Fe | Al | Na | Mn | Zn | Ba | Sr |
|---|---|---|---|---|---|---|---|---|---|---|---|
| C-1 | 10206 | 1451 | 9251 | 5484 | 6452 | 3801 | 932 | 140 | 5.95 | 107 | 96.3 |
| C-2 | 1081 | 756 | 9397 | 8970 | 6662 | 2678 | 693 | 83.3 | 1.44 | 80.5 | 97.4 |
| C-3 | N.D. | 3.9 | 117 | 62.8 | 51 | 33.1 | 12.4 | 0.9 | 242 | 0.97 | 1.05 |
| C-4 | 97.6 | 541 | 77.7 | 41.3 | 325 | 264 | 73.8 | 6.74 | 9.98 | 3.09 | 1.31 |
| C-5 | 742 | 12483 | 8205 | 1823 | 2100 | 3953 | 375 | 404 | 9.23 | 89.5 | 49.6 |
| C-6 | 140 | 1308 | 200 | 179 | 1025 | 914 | 293 | 13.3 | 5.69 | 5.54 | 3.61 |
| C-7 | 22.2 | 132 | 108 | 47 | 112 | 371 | 46 | 4.09 | 6.66 | 4.38 | 1.37 |
| C-8 | 14703 | 3245 | 982 | 393 | 602 | 491 | 417 | 38.6 | 8.96 | 6.95 | 6.26 |
| C-9 | 347 | 260 | 900 | 1042 | 1176 | 2381 | 423 | 18.2 | 1.9 | 29.5 | 15.4 |
| C-10 | 166 | 344 | 1223 | 630 | 453 | 1048 | 261 | 14.6 | 2.6 | 21.3 | 8.6 |
| Detection limit | 5.6 | 1.7 | 16 | 0.77 | 3.5 | 14 | 3.4 | 0.27 | 0.56 | 0.41 | 0.02 |
| Set No. | Cr | Rb | Cu | V | Ni | Pb | Co | Li | Ag | Be | Cd |
| C-1 | 60.7 | 3.35 | 11.6 | 15.6 | 6.57 | 2.2 | 2.81 | 2.56 | 0.03 | 0.91 | 0.02 |
| C-2 | 7.21 | 2.4 | 7.2 | 7.43 | 3.03 | 0.12 | 0.97 | 0.6 | 0.01 | 0.08 | 0.01 |
| C-3 | 4.89 | 0.02 | 3.32 | 0.74 | 2.11 | 11.7 | 0.3 | N.D. * | 0.03 | 0.28 | 0.02 |
| C-4 | 5.79 | 3.23 | 30.5 | 2.09 | 4.35 | 0.26 | 0.37 | 0.17 | 0.01 | 0.01 | 0.01 |
| C-5 | 4.23 | 62.4 | 16.8 | 4.86 | 3.53 | 1.09 | 1.1 | 4.5 | 0.02 | 0.14 | 0.03 |
| C-6 | 62.5 | 3.6 | 19.2 | 1.25 | 15.1 | 0.22 | 0.67 | 0.8 | 0.1 | 0.05 | 0.02 |
| C-7 | 13.9 | 0.82 | 12.5 | N.D. * | 3.45 | 0.21 | 0.13 | 0.17 | 0.24 | 0.04 | 0.02 |
| C-8 | 12.9 | 13.4 | 17 | 0.89 | 4.99 | 1.09 | 0.3 | 0.27 | 0.05 | 0.02 | 0.03 |
| C-9 | 7.34 | 0.85 | 8.86 | 2.65 | 3.73 | 0.21 | 0.84 | 0.29 | 0.02 | 0.1 | 0.01 |
| C-10 | 50.4 | 1.1 | 8.85 | 1.54 | 7.36 | 0.31 | 0.5 | 0.41 | 0.02 | 0.04 | 0.02 |
| Detection limit | 0.5 | <0.01 | 0.19 | 0.47 | 0.08 | 0.04 | <0.01 | 0.01 | <0.01 | <0.01 | <0.01 |
| A. bombycis MAFF111712 | A. nomius MAFF111739 | ||||||||
|---|---|---|---|---|---|---|---|---|---|
| PD 1 | PD | ||||||||
| — 1 | Ca 2 | Fe 2 | Mg 2 | — | Ca | Fe | Mg | ||
| AFG1 | 5.44 ± 0.69 | 4.72 ± 0.78 | 7.06 ± 1.32 | 9.89 ± 0.02 | AFG1 | 0.18 ± 0.03 | 0.25 ± 0.07 | 0.28 ± 0.05 | 0.35 ± 0.09 |
| AFB1 | 4.05 ± 0.53 | 3.00 ± 0.46 | 2.85 ± 0.47 | 4.93 ± 0.14 | AFB1 | 1.60 ± 0.24 | 1.55 ± 0.32 | 1.67 ± 0.30 | 1.03 ± 0.24 |
| AFG2 | 0.06 ± 0.01 | 0.05 ± 0.01 | 0.07 ± 0.01 | 0.08 ± 0.01 | AFG2 | 0.00 ± 0.00 | 0.00 ± 0.00 | 0.00 ± 0.00 | 0.00 ± 0.00 |
| AFB2 | 0.10 ± 0.01 | 0.07 ± 0.01 | 0.06 ± 0.01 | 0.08 ± 0.01 | AFB2 | 0.01 ± 0.00 | 0.01 ± 0.00 | 0.01 ± 0.00 | 0.01 ± 0.00 |
| A. bombycis MAFF111712 | A. nomius MAFF111739 | ||||||||
|---|---|---|---|---|---|---|---|---|---|
| PD with 0.3 g·L−1 C-31 | PD with 0.3 g·L−1 C-3 | ||||||||
| — 1 | Ca 2 | Fe 2 | Mg 2 | — | Ca | Fe | Mg | ||
| AFG1 | 5.44 ± 0.69 | 4.72 ± 0.78 | 7.06 ± 1.32 | 9.89 ± 0.02 | AFG1 | 0.18 ± 0.03 | 0.25 ± 0.07 | 0.28 ± 0.05 | 0.35 ± 0.09 |
| AFB1 | 4.05 ± 0.53 | 3.00 ± 0.46 | 2.85 ± 0.47 | 4.93 ± 0.14 | AFB1 | 1.60 ± 0.24 | 1.55 ± 0.32 | 1.67 ± 0.30 | 1.03 ± 0.24 |
| AFG2 | 0.06 ± 0.01 | 0.05 ± 0.01 | 0.07 ± 0.01 | 0.08 ± 0.01 | AFG2 | 0.00 ± 0.00 | 0.00 ± 0.00 | 0.00 ± 0.00 | 0.00 ± 0.00 |
| AFB2 | 0.10 ± 0.01 | 0.07 ± 0.01 | 0.06 ± 0.01 | 0.08 ± 0.01 | AFB2 | 0.01 ± 0.00 | 0.01 ± 0.00 | 0.01 ± 0.00 | 0.01 ± 0.00 |
© 2019 by the authors. Licensee MDPI, Basel, Switzerland. This article is an open access article distributed under the terms and conditions of the Creative Commons Attribution (CC BY) license (http://creativecommons.org/licenses/by/4.0/).
Share and Cite
Suzuki, T.; Toyoda, M. Metal Ions in Activated Carbon Improve the Detection Efficiency of Aflatoxin-Producing Fungi. Toxins 2019, 11, 140. https://doi.org/10.3390/toxins11030140
Suzuki T, Toyoda M. Metal Ions in Activated Carbon Improve the Detection Efficiency of Aflatoxin-Producing Fungi. Toxins. 2019; 11(3):140. https://doi.org/10.3390/toxins11030140
Chicago/Turabian StyleSuzuki, Tadahiro, and Masatoshi Toyoda. 2019. "Metal Ions in Activated Carbon Improve the Detection Efficiency of Aflatoxin-Producing Fungi" Toxins 11, no. 3: 140. https://doi.org/10.3390/toxins11030140
APA StyleSuzuki, T., & Toyoda, M. (2019). Metal Ions in Activated Carbon Improve the Detection Efficiency of Aflatoxin-Producing Fungi. Toxins, 11(3), 140. https://doi.org/10.3390/toxins11030140




